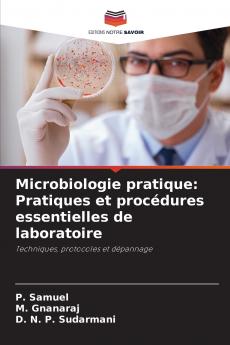
Microbiologie pratique
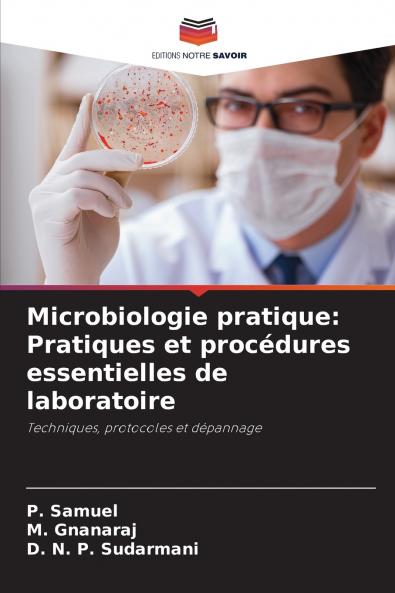
Microbiologie pratique

French
Paperback
₹6785
₹8542
20.57% OFF
(All inclusive*)
Delivery Options
Please enter pincode to check delivery time.
*COD & Shipping Charges may apply on certain items.
Review final details at checkout.
Looking to place a bulk order? SUBMIT DETAILS
Delivery Options
Please enter pincode to check delivery time.
*COD & Shipping Charges may apply on certain items.
Review final details at checkout.
About The Book
Description
Author(s)
Microbiologie pratique: pratiques et procédures essentielles de laboratoire - techniques protocoles et dépannage est méticuleusement conçu pour répondre aux besoins des étudiants de première année de licence en microbiologie et biotechnologie conformément au programme d'études défini par TANSCHE. Ce manuel essentiel offre une exploration approfondie des procédures de laboratoire en microbiologie fournissant aux étudiants les connaissances fondamentales et les compétences pratiques nécessaires pour réussir dans ce domaine. Conçu comme une ressource conviviale le livre couvre un large éventail de sujets y compris les techniques de culture microbienne les méthodes de coloration et les tests biochimiques. Chaque procédure est présentée de manière claire et concise accompagnée d'instructions et d'illustrations étape par étape pour faciliter la compréhension et la mise en œuvre. En mettant l'accent sur l'apprentissage pratique ce livre est un compagnon indispensable pour les étudiants qui se lancent dans le monde fascinant de la microbiologie.
Details
ISBN 13
9786207405312
Publication Date
-21-04-2024
Pages
-128
Weight
-184 grams
Dimensions
-152x229x7.64 mm